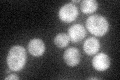
YDR017C
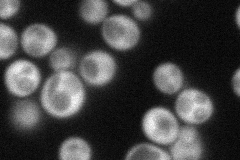
YDR017C
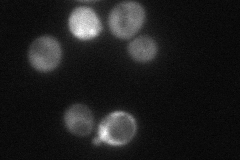
YDR017C
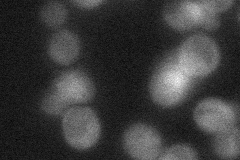
YDR017C
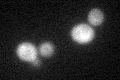
YDR017C
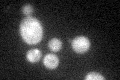
YDR017C
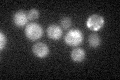
YDR017C

View description
Inositol hexakisphosphate (IP6) and inositol heptakisphosphate (IP7) kinase; generation of high energy inositol pyrophosphates by Kcs1p is required for many processes such as vacuolar biogenesis, stress response and telomere maintenance
Localization:
Intensity:
Fold change:
Significance:
-
C’ GFP library in SD
cytosol36.03 -
N' NOP1pr-GFP in SD
cytosol56.3847 -
N' TEF2pr-mCherry in SD
cytosol44.3415 -
N' NATIVEpr-GFP in SD
cytosol32.3547 -
N' TEF2pr-VC and Cyto-VN in SD

cytosol37.5268 -
C’ GFP library in SD+DTT
cytosol29.690.82No -
C’ GFP library in SD+H2O2
cytosol36.461.01No -
C’ GFP library in Starvation Media
cytosol32.540.9No -
C’ GFP library on the background of Pup2-DaMP

cytosol -
C’ GFP library on the background of CCT mutant

cytosol40.03571.11081No
